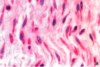

Histology of the Connective Tissue Flashcards
(36 cards)
what is connective tissue made from?
which cells are connective tissues derived from?
what are role of connective tissue cells?
- made from cells and ECM
- derived from mesoderm.
- role: storage of metabolites, immune / inflam reponse and tissue repair
whar are the different classifications of connective tissue?
- embryonic connective tissue
- mesenchyme
- mucous connective tissue
2. adult connective tissue
- loose connective tissue
- dense connective tissue
3. specialised connective tissue
- cartilage
- bone
- adipose tissue
- hemopoeitic tissue
- lymphatic tissue
what is mesenchyme?
what does embroynic mesenchyme give rise to?
- loose tissue
- found in embryo and umblical cord
- embryonic mesenchyme gives rise to muscle, vasuclar and uro-genetial systems and serous membranes
explain the one type of embryonic connective tissue
mesenchyme
- embryo
- small spindle shaped
- ECM is filled with viscous ground substance
- collagen fibres are very fine and relatively sparse
explain the second type of embryonic connective tissue
mucous connective tissue (wharton’s jelly)
- umbilical cord -> protects umbilical cord vessels (fibroblasts, macrophages)
- cells are seperated and look like fribroblasts
- thin collagen fibres

how do we classify adult connective tissue?
what is adult connective tissue derived from
classifications:
- amount / number of collagen fibres
- organisation of collagen fibres
- type of collagen fibres
derived from: fibroblasts
what are two types of adult connective tissue?
loose connective tissue
dense connective tissue
for loose connective tissue, explain
a) structure
b) location
c) the site of what?
d) morphology?
loose connective tissue
structure:
a) thin and few fibres, but more cells.
b) abundant gel-like ground substance (facilitates diffusion of small molecules)
location: beneath epithelial tissue (generally mucose or submucosa around BV, nerves, muscles)
site of: inflammatory and immune response
morphology: collagen fibres are thicker than elastic fibres, fibroblasts and mast cells presnet

what are the two types of dense connective tissue?
regular and irregular dense connective tissue
what is dense regular connective tissue characterised by?
what is dense regular connective tissue the main functional component of ?
dense regular connective tissue
- densely packed arrays of fibres and cells, all go same direction
- good resistance to pulling forces
- can stretch
- little ECM (c.f. loose connective tissue and irregular connective tissue)
- parralel bundles of collagen fibres (wavy appearance) and rows of fibroblasts - fibroblasts known as tendinocytes are surrounded by specialised ECM that seperates them from collagen fibres.
main functional component of:
- tendons, ligaments and cornea

what are differences between tendons and ligaments?
tendons
- MUSCLE TO BONE
ligaments
- fibres are less regularly arranged
- BONE TO BONE
- can provide some elasticity
describe the structure of dense irregular connective tissue
- mostly collagen fibres. few cells (of fibroblasts)
- fibres are arranged in bundles in various directions (unlike dense regular connective tissue)
- in hollow organs -> esp. submucosa (layer beneath epi. lining of organ)
- allow stretching and distension
what is dense connective tissue type called that has more elastic tissue?
elastic tissue lol
- found between vertabrae
what are the three types of connective tissue fibres?
1. collagen fibres
2. reticular fibres / tissue
3. elastic tissue
- describe collagen fibre macrostructure
- what do collagen fibres look like under a) light and b) electron microscope?
macrostructure: triple helix of 3 polypeptides
shape: a) light microscope - wavy appearance. b) electron micrscope - bundles of fine, threadlike units
(need to know what stain?)
- name strongest to weakest type of collagen
- stength:
- type 1, type 2, type 3, type 4:
- strongest —————> weakest
- where are each type found?
where is type 1 collagen found?
- type 1: bones, skin, tendons, fascia, cornea, teeth, mature scars
where is type 2 collagen found?
cartilage, vitreous humor
where is where is type 3 collagen found?
embroynic tissue, uterus, blood vessels
where is type 4 collagen found?
basal membane
where are reticular fibres found?
what do they support?
what associated with?
what is layout of cells like?
what made from?
what ar produced by?
- supporting stroma for highly cellular organs (like liver).
- found at boundary of connective tissue and epithelium.
- wound healing and scar tissue.
- branching pattern -> loose to allow passage of cells and fluid
- made of type III collagen. dont bundle
- produced by fibroblasts

elastic fibres:
- where found?
- what look like?
- structure like compared to collagen?
- (stained with?)
- found in ligaments of vertebral column
- spring-like appearance
- thinner than collagen fibres
- (stained with orcein)

what is ECM made of?
- proteoglycans
- collagens
- noncollagenous glycoproteins (fibronectin and laminin)









